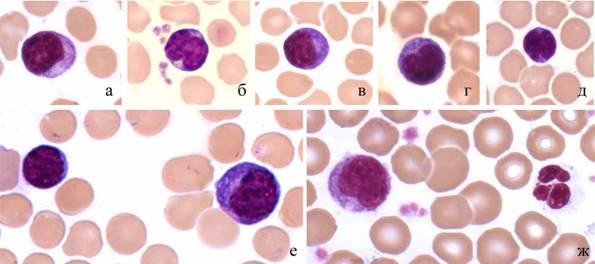

На правах рукописи
МОРФОЛОГИЧЕСКИЕ И ЦИТОХИМИЧЕСКИЕ ОСОБЕННОСТИ КЛЕТОК КРОВИ МОРСКИХ МЛЕКОПИТАЮЩИХ В СВЯЗИ С АДАПТАЦИЕЙ К СРЕДЕ ОБИТАНИЯ
03.03.01 – физиология
03.02.04 – зоология
Автореферат диссертации на соискание ученой степени
доктора биологических наук
Петрозаводск – 2011
Работа выполнена в Мурманском морском биологическом институте Кольского научного центра Российской академии наук
Научный консультант:
Доктор биологических наук
Официальные оппоненты:
Доктор биологических наук
Доктор биологических наук, профессор
Доктор ветеринарных наук, профессор
Ведущая организация:
Мурманский государственный технический университет
Защита диссертации состоится " 24 " ноября 2011 года
на заседании диссертационного совета ДМ212.087.02 при Карельской государственной педагогической академии 7.
С диссертацией можно ознакомиться в библиотеке Карельской государственной педагогической академии
Автореферат разослан " "__________________2011 года
Ученый секретарь
диссертационного совета
кандидат медицинских наук, доцент
ОБЩАЯ ХАРАКТЕРИСТИКА РАБОТЫ
Актуальность проблемы. Естественная среда обитания морских млекопитающих постоянно ухудшается в результате загрязнения океана. Все усложняющиеся условия проживания, вопросы сохранения здоровья целых популяций животных привели в настоящее время биологическую науку к осознанию необходимости детального изучения процессов адаптации к меняющимся условиям окружающей среды. Заболевания и гибель содержащихся в океанариумах животных являются важнейшими факторами, препятствующими разведению водных млекопитающих. Проблема оценки эффективности механизмов резистентности к воздействию неблагоприятных факторов актуальна не только для содержащихся в неволе и редких, но и для промысловых видов морских млекопитающих, численность которых существенно снижается из-за распространяющихся в последние годы интоксикаций и эпизоотий (Бобовникова и др., 1986; Алмквист и др., 1987; Harwood, Rejnders, 1988; Хураськин и др., 2002).
Особенности строения и функционирования системы крови и лимфоидной системы могут играть существенную роль в патогенезе заболеваний у морских млекопитающих, эволюционировавших в чистой океанической среде, не содержавшей патогенных микроорганизмов суши (Сыкало, 1982; Arvey, 1976; Cavagnolo, 1979; Baiker, 1984). В то же время, лимфоидная система китообразных и ластоногих, как и система крови в целом, изучены недостаточно для определения их функциональных возможностей.
Помимо клинической диагностики, кровь и органы гемопоэза являются объектами для исследования организмов разного филогенетического уровня, обитающих в различных экологических условиях. В этом отношении морфологические и функциональные характеристики отдельных гемопоэтических ростков в каждом классе и отряде позвоночных имеют существенные различия (Заварзин, 1985; Горышина, Чага, 1990; Галактионов, 2005). С таких позиций, интерес к сравнению наземных и водных млекопитающих связан с тем, что они обитают в разных средах, а это, несомненно, отразилось на механизмах кроветворения и иммунной защиты.
Несмотря на значительные успехи исследований плазмы и клеток крови в норме и при патологии, заболеваемость и смертность мелких китообразных и ластоногих остаются на высоком уровне. Основной причиной этого являются вирусные, бактериальные и грибковые инфекции (Захарова, Дралкин, 1985; Воронков, 1990, 1992; Денисенко, 2003; Денисенко, Соколова, 2008; Шестопалов и др., 2010; Raethel, 1962; Ridgway, 1975; Cordes, 1982; Pilleri, 1983; Murmann et al., 1984; Daniel, 1985; Schumacher et al., 1990).
Большая часть исследований крови, связанных с проблемами токсикологии и заболеваний морских млекопитающих, выполняется биохимическими методами, изучение клеток играет, как правило, подчиненную, вспомогательную роль. Данные о морфофункциональных характеристиках, качественном и количественном составе клеток крови в научной литературе немногочисленны.
Результаты исследований, осуществленных на неоднородных по возрасту, полу и условиям обитания группах морских млекопитающих разных видов не дают возможности сформировать единое представление об адаптивных изменениях в организме, происходящих в новых для него экологических условиях, раскрыть механизмы этих изменений. Мало изучены вопросы, связанные с влиянием ноогенных условий на клеточный иммунитет, а работы, посвященные исследованию этой проблеме в период адаптации к неволе вообще единичны (Романов, Сергиевская, 1989; Швацкий и др.1990, Романов, 1991; Матишева, Шапунов, 1990; Соколова, 2002, 2006). Отсутствуют комплексные исследования, позволяющие оценить связь адаптивных изменений, развивающихся на клеточном и субклеточном уровне, с регуляторными влияниями организма.
В экспериментальных и клинических исследованиях установлено, что определение клеточного состава крови по морфологическим и цитохимическим признакам позволяет не только определять, но и прогнозировать состояние систем специфического и неспецифического иммунитета и организма в целом (Соколов и др.,1975; Голубева и др., 1978; Исаева, 1980; Комиссарова, 1983; Нарциссов, 1984, 1988; Робинсон и др., 1986; Гольдберг, Новицкий, 1986; Нагоев, 1988; Летягин, Шурлыгина, 1987).
Проведение комплексных исследований с изучением морфологии и метаболизма клеток крови морских млекопитающих различных видов дает возможность выяснить механизмы приспособительных изменений, связанных с водной средой обитания, происходящих на клеточном уровне, а также при адаптации к новым экологическим условиям и при различных физиологических и патологических состояниях.
Цель исследования. Выявить характер и закономерности изменений качественного и количественного состава клеток периферической крови представителей китообразных и ластоногих по морфологическим и цитохимическим признакам в связи со спецификой среды обитания, а также в различные периоды адаптационного процесса в условиях неволи.
Для достижения цели были поставлены следующие задачи.
1. Провести сравнительный цитологический и цитохимический анализ, дать характеристику особенностей клеток крови дельфинов и тюленей.
2. Определить возрастные особенности клеточного состава крови тюленей.
3. Выяснить структуру популяции лимфоцитов периферической крови дельфинов афалин для поиска критериев оценки состояния лимфоидной системы, ее зависимость от физиологического статуса животных. Выявить изменения гематологических показателей при адаптации дельфинов и тюленей к условиям неволи.
4. Определить цитологические и цитохимические показатели при воздействии различных иммуномодулирующих и экстремальных факторов на дельфинов и тюленей.
Научная новизна результатов работы. Впервые в природных условиях и у адаптирующихся к неволе тюленей выявлено уравнивание на определенных этапах индивидуального развития числа лимфоцитов и нейтрофилов – "физиологический перекрест" лейкоцитарной формулы крови, обусловленный формированием системы специфического иммунитета. Установлено, что изменения клеточного состава крови у тюленей на ранних этапах адаптации к условиям неволи (3 недели) в значительной степени обусловлены стрессом. После 10-12 месяцев адаптации цитохимическая структура популяции лимфоцитов крови стабилизируется.
Впервые проведено сравнительное морфологическое и морфометрическое исследование районов организаторов ядрышка лимфоцитов периферической крови представителей морских млекопитающих девяти видов. Создана основа для оценки изменений в важнейшей части генома, связанной с синтезом белков, в онтогенезе, при заболеваниях, различных физиологических состояниях у китообразных и ластоногих. Показано, что активность ядрышкового аппарата лимфоцитов серого и гренландского тюленей снижается с возрастом, отражая интенсивность развития лимфоидной системы в различные периоды раннего постнатального онтогенеза.
Показано, что лимфоциты дельфинов афалин различаются по количеству и характеру внутриклеточного распределения окрашенных продуктов цитохимических реакций на неспецифическую эетеразу, сукцинатдегидрогеназу, НАДН - и НАДФН-тетразолий редуктазы, гликоген, нуклеиновые кислоты, в состав популяции лимфоцитов периферической крови афалин входят две группы клеток – с высокой и с низкой активностью неспецифической эстеразы и дегидрогеназ, аналогичные выявляемым у наземных млекопитающих. Установлено, что корреляции между цитохимическими характеристиками популяции лимфоцитов афалин соответствуют особенностям внутриклеточных метаболических процессов. Найдено, что состав популяции лимфоцитов по активности неспецифической эстеразы и сукцинатдегидрогеназы, сила и направленность корреляций параметров распределения лимфоцитов по активности этих ферментов и числа гликогенсодержащих лимфоцитов различны у здоровых, больных инфекционными заболеваниями, адаптированных и не адаптированных к условиям неволи афалин.
Впервые проведено комплексное исследование морфологических и структурно-метаболических показателей клеточного cостава крови в процессе систематического наблюдения за группами морских млекопитающих, пребывающих в различных условия. Показаны пути адаптации, связанные с водным образом жизни, сходные у китообразных и ластоногих.
Практическая и теоретическая значимость работы. Результаты изучения механизмов формирования экологически обусловленного уровня резистентности организма дельфинов и тюленей могут быть использованы для разработки профилактических мероприятий, методов контроля адаптации иммунной системы в новых условиях проживания. Полученная информация позволяет понять и оценить предпосылки формирования иммунодефицитных проявлений, достаточно часто встречающихся в условиях загрязнения воздушной и водной среды обитания, расширить представления об эволюции системы крови. Результаты работы могут использоваться при объяснении механизмов изменений, происходящих на клеточном уровне, как при адаптации человека и животных к новым условиям обитания, так и для лучшего понимания механизмов специфических и неспецифических адаптационных реакций.
Полученные материалы используются при чтении лекционных курсов и проведении практических занятий для студентов биологического факультета Мурманского государственного технического университета.
Основные положения, выносимые на защиту. 1. Период становления костномозгового кроветворения у детенышей тюленей занимает относительно большую часть постнатального онтогенеза, чем у наземных млекопитающих. Это, вероятно, обусловлено меньшим количеством костного мозга у ластоногих и мелких китообразных, обладающих в связи с водным образом жизни более легким скелетом.
2. Структура популяции лимфоцитов по морфологическим и цитохимическим признакам адекватно отражает изменения, происходящие в системе крови дельфинов и тюленей с возрастом, при изменениях иммунологического статуса и воздействии экстремальных факторов. Показатели клеточного состава крови и структурно-метаболического статуса лимфоцитов могут быть использованы для оценки течения процесса адаптации и зависят от регуляторных влияний целостного организма на различных его этапах.
3. Морфологическое и цитохимическое изучение клеток крови дельфинов и тюленей позволяет различать особей, по-разному реагирующих на воздействие иммуномодулирующих и экстремальных факторов. Неадаптированные к условиям неволи афалины отличаются от адаптированных высоким уровнем корреляций между параметрами распределения лимфоцитов по активности неспецифической эстеразы, сукцинатдегидрогеназы и содержания гликогена, т. е., более высокой метаболической активностью лимфоидной системы. Резкие колебания состава лимфоцитов при состояниях, сопровождающихся иммунодепрессией, можно рассматривать как косвенное доказательство сниженной иммунологической реактивности морских млекопитающих в современной среде обитания.
Апробация материалов диссертации. Результаты работы докладывались и обсуждались на 8 и 9 Всесоюзных совещаниях по изучению, охране и рациональному использованию морских млекопитающих (Астрахань, 1982; Архангельск, 1986); I съезде анатомов, гистологов, эмбриологов Белоруссии (Минск, 1984); Всесоюзной конференции по физиологии морских животных (Мурманск, 1989); Международном симпозиуме по изучению морских млекопитающих (Tromsø, Норвегия, 1994); евро-американском конгрессе по изучению млекопитающих (Santiago de Compostela, Испания, 1998); VI и VII съездах Териологического общества РАН (Москва, 1999, 2003); международных научно-технических конференциях "Наука и образование" (Мурманск, 2005, 2007); I Съезде физиологов СНГ (Сочи, 2005); 13 Международном совещании по эволюционой физиологии (СПб, 2006); Международной научно-практической конференции "Морские биотехнические системы. Биологические и технические аспекты" (Ростов-на-Дону, 2008); II международной конференции "Актуальные проблемы экологической физиологии, биохимии и генетики животных" (Саранск, 2009); 4 международном симпозиуме "Современные проблемы и методы экологической физиологии и патологии млекопитающих, введенных в зоокультуру" (Петрозаводск, 2009); на I-VI конференциях "Морские млекопитающие Голарктики" (Архангельск, 2000; Иркутск, 2002; Коктебель, 2004; Санкт-Петербург, 2006; Одесса, 2008; Калининград, 2010).
Публикации. Всего по теме диссертации опубликовано 96 научных работ, в том числе 15 в ведущих научных журналах, перечень которых утвержден ВАК.
Структура и объем работы. Диссертация изложена на 242 страницах, состоит из введения, обзора литературы, главы "Материалы и методы исследования", 4-х глав с результатами исследований и их обсуждением, заключения, выводов, списка литературы, включающего 409 источников, из которых 206 на русском языке, содержит 77 рисунков и 32 таблицы.
СОДЕРЖАНИЕ РАБОТЫ
Глава 1 ЗНАЧЕНИЕ ИССЛЕДОВАНИЙ КРОВИ МОРСКИХ МЛЕКОПИТАЮЩИХ (обзор литературы)
Показано, что, несмотря на многолетний опыт изучения плазмы и клеток крови биохимическими и иммунологическими методами как в природных условиях, так и в условиях неволи, целостное представление об адаптационных возможностях морских млекопитающих отсутствует. Детальные исследования морфологии, свойств и функций клеток крови этих животных единичны. В результате анализа данных литературы, свидетельствующих о высокой диагностической и прогностической ценности комплексного применения морфологических и цитохимических методов, обосновываются цель и задачи исследования.
На основании анализа литературных данных представлены сведения о различных формах патологии у морских млекопитающих. Рассмотрены результаты исследований, посвященных проблеме оценки и охраны здоровья китообразных и ластоногих. Подчеркивается, что необходим переход с ретроспективно-констатационного на прогностическое направление исследований.
Глава 2 МАТЕРИАЛЫ И МЕТОДЫ ИССЛЕДОВАНИЯ
Объекты исследования: дельфин афалина (Tursiops truncatus), обыкновенная морская свинья (Phocoena phocoena), белуха (Delphinapterus leucas), гренландский (Phoca groenlandica) и серый (Halichoerus grypus) тюлени, тюлень-хохлач (Cystophora crystata), морской заяц (Erignatus barbatus), кольчатая нерпа (Phoca hispida), северный морской котик (Callorhinus ursinus). Материалы были получены в дельфинарии г. Севастополя (после 1991г. – Государственный океанариум Украины), на морской биологической станции ИПЭЭ РАН (пос. Малый Утриш); в аквариальном комплексе ММБИ; во время береговых экспедиций на острова прибрежья Мурмана и на зверобойном промысле (пос. Чапома Мурманской области, пос. Койда Архангельской области).
Общее число исследованных животных составило: афалина – 55; белуха – 2; обыкновенная морская свинья – 6; гренландский тюлень – 256; серый тюлень – 36; тюлень-хохлач – 13; кольчатая нерпа – 5; морской заяц – 2; северный морской котик – 1.
Методики исследования. Кровь у дельфинов и белух брали при помощи стерильной иглы для подкожных инъекций длиной 30 мм и диаметром 1.2 мм по методике, описанной С. Риджвеем и соавторами (Ridgway et al., 1970). Взятие крови у тюленей осуществляли из внутрипозвоночной (экстрадуральной) вены (Geraci, Smith, 1975) при помощи иглы для спинномозговой пункции в шприц с гепарином, удерживая тюленя в неподвижном состоянии 2-3 мин.
Изготовленные общепринятым способом мазки цельной крови и лейкоцитарного концентрата окрашивали смесью Романовского. Применяли также следующие цитохимические методики. Выявление ферментов: неспецифической эстеразы (Müller et al., 1975, в модификации) – для оценки состояния лизосомного аппарата; сукцинатдегидрогеназы (Quaglino, Hayhoe, 1960; Нарциссов, 1969) как ключевого фермента цикла Кребса; НАДН - и НАДФН-тетразолий редуктаз (Novikoff, Masek, 1958) – в качестве показателей общей интенсивности окислительных процессов в клетке. Выявляли также гликоген (McManus, 1946; Hochkiss, 1948), суммарное количество нуклеиновых кислот при окрашивании смесью галлоцианин-хромовые квасцы (Boer, Sarnaker, 1956), белки районов организаторов ядрышка (Howell, Black, 1980). Препараты исследовали при увеличении 1000 (объектив ×100, окуляр ×10). Морфометрическое исследование лимфоцитов проводили на компьютерных анализаторах изображений "Omnicon" (США, модель FAS-2) и AxioVision, версия 4.5 (Германия, CarlZeiss Vision). Мерой активности ферментов и содержания нуклеиновых кислот служила интегральная оптическая плотность, активности ядрышек – относительная площадь районов организаторов ядрышка.
Математические методы анализа результатов. Обработку полученных результатов проводили при помощи пакетов программ Statsoft Statistica V6.0, Exel, Systat 5W. При статистических оценках и сравнениях клеточного состава крови по морфологическим и цитохимическим признакам использовали стандартные параметрические и непараметрические методы (Урбах, 1963). Для оценки структуры популяции лимфоцитов по цитохимическим признакам использовали следующие характеристики: средняя (М); среднеквадратичное отклонение (S); коэффициент вариации (V); показатели асимметрии (As) и эксцесса (Ex), энтропия (H), информационная избыточность (R). H = –ΣP×logP, где P – относительная частота клеток в данном классе гистограммы; R=((Hm – H)/Hm)×100, где Hm – энтропия, максимально возможная для гистограммы с данным числом классов – при равенстве частот всех классов, H – действительная энтропия гистограммы. Информационный анализ проводили в соответствии с методическими рекомендациями и соавторов (1981).
В качестве показателей для оценки особенностей клеточного состава крови при сравнении групп животных и отдельных особей применяли критерии Колмогорова-Смирнова, χ2, Стьюдента. При анализе субпопуляционного состава лимфоцитов использовали методы аппроксимации распределений нормальными, гауссовыми (Урбах, 1963; Bhattacharia, 1969). Достоверность значений статистических параметров и сходства-различия при статистических сравнениях оценивали при уровнях значимости 0.95 и 0.99.
Глава 3 МОРФОЛОГИЯ И ЦИТОХИМИЯ КРОВИ ДЕЛЬФИНОВ И ТЮЛЕНЕЙ
3.1 Морфологическая характеристика различных типов клеток крови дельфинов и тюленей
В окрашенных по Романовскому-Гимза мазках крови афалин, обыкновенных морских свиней и белух наиболее многочисленный тип лейкоцитов – нейтрофилы. Гранулоцитарный профиль лейкоцитарной формулы крови характерен и для тюленей. Однако в некоторые периоды раннего постэмбрионального развития у серых, гренландских и тюленей хохлачей, как и у ряда исследованных в данном отношении наземных животных, число лимфоцитов достигает уровня нейтрофилов либо превышает его. Цитоплазма нейтрофильных гранулоцитов тюленей, как правило, окрашивается менее интенсивно, чем у дельфинов. Гранулы слабо различимы. Такая же особенность окрашивания по Романовскому-Гимза свойственна нейтрофилам наземных хищных млекопитающих – собак и кошек (Риган и др., 2000). Большинство гранулоцитов тюленей имеют сегментированыые или палочковидные ядра. Однако у новорожденных и кормящихся молоком серых и гренландских тюленей в значительном числе встречаются юные, т. е., низкодифференцированные клетки гранулоцитарного ряда, метамиелоциты. Метамиелоциты присутствуют также у дельфинов афалин, как больных, так и здоровых.
В мазках крови серых тюленей встречаются клетки с сегментированным ядром и розовыми цитоплазматическими гранулами неправильной формы с размытыми границами, "гетерофилы". Их число у обследованных серых тюленей составляет 0-2.5% от всех гранулоцитов. Такие лейкоциты выявляются у собак (Риган и др., 2000). Гетерофилы – обычный компонент крови сиреновых (Bossart, Bigger, 1994; Bossart et al., 2001). Они дают положительную реакцию на миелопероксидазу (МПО), подобно нейтрофилам человека, собаки, кошки и лошади (Kiehl, Schiller, 1994).
Сопоставление результатов морфологического исследования и выявления миелопероксидазы в мазках крови серых тюленей свидетельствует, что гетерофилы серых тюленей также МПО–положительны. Это позволяет отнести их к нейтрофильному ряду. Другой заметной особенностью состава крови серых тюленей является наличие гигантских тромбоцитов, обычного компонента крови кошек, вне зависимости от состояния животных (Риган и др., 2000).
Среди гранулоцитов тюленей встречаются клетки с ядрами необычной формы: отдельные сегменты соединены друг с другом нитями хроматина, сходящимися в одной точке (рис. 1), а не последовательно, как у человека, лабораторных и сельскохозяйственных животных (Никитин, 1956; Кудрявцев и др., 1969; Абрамов, 1985; Риган и др., 2000). Это, вероятно, является одной из особенностей дифференцировки части клеток миелоидного ростка кроветворения у тюленей. Выявлены также лейкоциты, представляющие, по-видимому, предшествующую стадию дифференцировки (рис. 1г).
У дельфинов и белух клетки с характерными признаками базофильных гранулоцитов не обнаружены. В мазках крови тюленей они присутствуют, однако не во всех случаях. Ядро этих клеток, как правило, не сегментировано, по размеру они больше нейтрофилов и зозинофилов. По литературным данным, их число у ластоногих невелико: 0–2 % (Medway, Geracy, 1964; Ridgway et al., 1970; Богданова, Лебедев, 1971; Monte, Pilleri, 1979; Engelhardt, 1979), а у китообразных они, как правило, не выявляются.

Рис. 1. Лейкоциты тюленей с ядрами необычной формы. Масляная иммерсия, объектив 100×.
Среди лимфоидных клеток дельфинов, белух и тюленей наиболее часты типичные малые лимфоциты с узким ободком базофильной цитоплазмы. Некоторые из лимфоцитов дельфинов и тюленей имеют необычную форму ядра: 2 выемки на одном полюсе и третья, менее глубокая, – на другом (рис. 2д).
Кроме типичных малых и средних лимфоцитов как у здоровых дельфинов, так и у афалин с кожными и респираторными инфекциями присутствуют лимфоциты больших размеров с признаками активации. Ядра этих клеток округлые, реже почковидные, хроматин рыхлый, цитоплазма сильно базофильна (рис. 2е, ж).
Рис. 2. Лимфоциты серого тюленя: а-д – малые лимфоциты; е – малый и большой лимфоциты; ж – большой лимфоцит и нейтрофил. Масляная иммерсия, объектив 100×.
Большие лимфоциты выявлены у всех исследованных детенышей тюленей. Небольшое количество таких клеток (2-5%) встречается и у взрослых гренландских тюленей. У некоторых щенков гренландского тюленя ("заморышей" и "нормальных") число больших лимфоцитов повышено (20-25%). Больные пневмонией белухи и обыкновенные морские свиньи в начале отравления нефтепродуктами также отличались повышенным (15-20%) содержанием больших лимфоцитов.
В цитоплазме части средних лимфоцитов различимы азурофильные метахроматически окрашенные гранулы, часто очень мелкие, на пределе разрешающей способности светового микроскопа. Их число колеблется от единиц до десятков Азурофилией (на электронно-микроскопическом уровне – осмиофилией) обладают лимфоциты, осуществляющие естественную, не индуцированную иммунизацией, цитотоксичность против опухолевых и инфицированных вирусами клеток (Малыгин, 1985). Такие клетки, "большие гранулярные лимфоциты" (БГЛ), выявлены нами у всех представителей изучаемых видов дельфинов и тюленей. БГЛ, вероятно, являются предшественниками Т-лимфоцитов в эволюции системы иммунитета позвоночных (Jams, 1988). Соотношение БГЛ, других субпопуляций лимфоцитов, а также гранулоцитов и моноцитов может быть использовано как показатель, отражающий потенциальный уровень клеточных защитных реакций различной степени специфичности.
Моноциты дельфинов, морских свиней и белух отличаются большим разнообразием по величине клетки, форме, плотности и относительным размерам ядра. Часть их содержит в цитоплазме мелкие азурофильные гранулы. В типичных случаях ядро бобовидное, подковообразное или неправильной формы с одной или несколькими лопастями. Некоторые моноциты небольших размеров сходны с лимфоцитами (рис. 3).
Тем не менее, судя по структуре хроматина и характеру окрашивания цитоплазмы, принадлежность этих клеток к моноцитарному ряду более вероятна. Подобные трудности при различении моноцитов и лимфоцитов китообразных отмечают Т. Монт и Г. Пиллери (Monte, Pilleri, 1979).

Рис. 3. Лейкоциты афалин: нейтрофил, эозинофил и моноцит. Масляная иммерсия, объектив 100×.
Моноциты тюленей менее разнообразны по морфологии ядра. Как правило, это клетки больших размеров (больше гранулоцитов), с многолопастным светлым ядром неправильной формы. В цитоплазме этих клеток зачастую присутствуют вакуоли диаметром 0.5-2 мкм.
В крови тюленей присутствуют предшественники эритроцитов, базофильные и полихроматофильные нормоциты. Особенно часто они встречаются у новорожденных животных. В мазках крови последних содержатся также предшественники нормоцитов, пронормоциты. И для бельков, и для серок тюленей характерны анизоцитоз и гипохромность эритроцитов. Костномозговое кроветворение новорожденных тюленей находится на стадии становления. Кроме того, тюлени в течение голодания после молочного вскармливания и ювенильной линьки не получают железа, витамина В12 и других веществ, необходимых для нормального кроветворения. Это может обусловить и анизоцитоз эритроцитов, и наличие в периферической крови нормоцитов. Оксифильные и полихроматофильные нормоциты а также гипохромные эритроциты постоянно встречаются также в мазках крови взрослых дельфинов.
1.2 Цитохимические реакции в лейкоцитах морских млекопитающих
Неспецифическая эстераза. Лейкоциты изученных китообразных и ластоногих различаются интенсивностью и характером реакции на неспецифическую эстеразу (НЭ). Гранулоциты афалин, морских свиней и белух в большинстве случаев проявляют реакцию в виде слабой диффузной окраски (рис. 4г), иногда эстеразоотрицательны. Наиболее высока активность фермента в моноцитах. Продукт реакции распределен в них диффузно, закрывая часть ядра, которое выглядит как более светлая область на коричневом фоне (рис. 4м).
Рис. 4. Неспецифическая эстераза в клетках крови афалины: Л – лимфоциты; М – моноцит; Г – гранулоциты; Э – эритроциты. Лейкоцитарный концентрат, масляная иммерсия, объектив 100×.
В моноцитах НЭ находится в клеточной мембране, в то время как в лимфоцитах она связана главным образом с лизосомами и лишь изредка обнаруживается на мембране клетки (Bozdeh, Bainton, 1981; Boesen, 1984).
В гранулоцитах тюленей, в отличие от дельфинов и белух, активность НЭ, как и в моноцитах, высока. Она проявляется в виде диффузных отложений окрашенного продукта реакции, часто закрывающих часть ядра. Характерно, что гранулоциты норки и песца также имеют высокую активность НЭ (Uzenbaeva, 1989). Это представляет интерес, поскольку предками тюленей были древние хищные.
Лимфоциты разнообразны по размерам, форме, числу и локализации зон, содержащих окрашенный продукт реакции. Число последних варьирует от 1 до 20 и более в одном лимфоците. Величина гранул колеблется в широких пределах: от долей до нескольких микрометров. Наиболее крупные из них располагаются напротив выемки в ядре, где у лимфоцитов находится основная масса цитоплазмы.
При визуальном микроскопическом исследовании различимы два типа реакции на НЭ: "гранулярная" (рис. 5в) и "парануклеарная" (рис. 5г). Тип эстеразной реакции лимфоцитов, при котором часть цитоплазмы напротив выемки в ядре заполнена окрашенным ее продуктом, обозначают как "глобулярный" (Treves, Ali-Khan, 1983), "крупногранулярный" (Уманский и др., 1981), "парануклеарный". Мы применяем термины, использованные авторами, представившими ультраструктурные и иммунологические характеристики лимфоцитов с различными типами эстеразной реакции (Ferrarini et al., 1980; Zicca et al., 1981). Реакцию парануклеарного типа на неспецифическую эстеразу, бета-глюкуронидазу и кислую фосфатазу проявляют нулевые клетки, Т-лимфоциты-супрессоры и киллеры. Гранулярная реакция характерна для Т-клеток-хелперов и части В-лимфоцитов.
Рис. 5. Особенности распределения окрашенного продукта эстеразной реакции в клетках крови дельфинов: а и б – в моноцитах и гранулоцитах; в и г – в лимфоцитах и гранулоцитах. б – ядра не окрашены, а, в, г – ядра окрашены толуидиновым синим. Масляная иммерсия, объектив 90×.
Оба типа локализации окрашенного продукта эстеразной реакции выявлены нами в мазках крови и лейкоцитарного концентрата афалин, обыкновенной морской свиньи, белухи, серого и гренландского тюленей, морского зайца, кольчатой нерпы, тюленя-хохлача, северного морского котика.
Дегидрогеназы. При использовании в реакционной смеси в качестве красителя (акцептора электронов) нитро-тетразолия синего (Novikoff, Masek, 1958; Quaglino, Hayhoe, 1960) наблюдается окрашивание в виде диффузных отложений и отдельных гранул. Последний тип реакции характерен для сукцинатдегидрогеназы (СДГ). В реакциях на НАДН - и, в особенности, НАДФН-тетразолий редуктазу преобладает диффузная окраска. Эти различия вполне объяснимы известными данными биохимии о внутриклеточной локализации и функциях окислительных ферментов (Ленинджер, 1985).
Характер реакции на СДГ с пара-нитротетразолием фиолетовым при ее выявлении по методу (1969) для визуальной количественной оценки активности дегидрогеназ отличается от описанного выше. Весь продукт реакции сосредоточен в отдельных гранулах одинакового размера.
Гликоген. В отличие от прочих лейкоцитов, окрашивающихся диффузно, содержащие гликоген (ШИК-положительные) лимфоциты афалин, морских свиней и белух содержат гранулы ярко-красного цвета.
Такой тип реакции характерен для лимфоцитов человека и других наземных млекопитающих (Бутенко и др., 1974; Кисляк, Ленская, 1978; Хейхоу, Кваглино, 1983). Гранулы чаще всего одиночные, изредка образуют замкнутое кольцо вокруг ядра. По форме они, как правило, округлые, но бывают и овальными а также неправильной формы.
Только у 48 из 205 щенков гренландского тюленя обнаружены содержащие гликоген лимфоциты (1-2%). Это можно было бы объяснить отрицательным энергетическим балансом детенышей во время голодания после молочного вскармливания. Однако взрослые гренландские тюлени также имеют невысокое число лимфоцитов, дающих положительную реакцию на гликоген (1-5%). У людей до одного года значения этого показателя составляют 33-84%, от 16 до 35 лет – 16-32%, от 36 до 60 лет – 6-26% (Лецкий, 1973). В лимфоцитах взрослых особей и щенков серого тюленя и кольчатых нерп, половозрелых самца и самки морских зайцев, северного морского котика гликоген нами не выявлен. Лимфоциты собак также, как правило, ШИК-отрицательны (Бутенко и др., 1974).
Белки районов организаторов ядрышка (ЯОРAg). Белки ядрышек, участвующие в процессах биосинтеза и созревания пре-рРНК, окрашиваются солями серебра (Crocker, 1990). Число и размеры ЯОРAg лимфоцитов крови – видоспецифичные признаки. Они изменяются при нарушениях в соответствующих участках генома и патологических состояниях (Mayr et al.., 1983). В лейкоцитах исследованных представителей китообразных и ластоногих выявляются от 1 до 4-х ЯОР. Это согласуется с результатами цитогенетическими исследований: кариотип соматических клеток исследуемых видов морских млекопитающих содержит 2 пары хромосом с организаторами ядрышка (Arnason, 1974, 1981). Лимфоциты, моноциты и гранулоциты дельфинов и тюленей различаются по размерам, форме, числу и локализации ЯОРAg (рис. 6).
Рис. 6. Окрашенные серебром районы организаторов ядрышка в клетках крови серого тюленя: а, б – сегментоядерный и палочкоядерный гранулоциты; в – эозинофил; г – лимфоцит; д – моноцит; е – нормоцит и лимфоцит.
Таким образом, клетки крови дельфинов и тюленей проявляют высокий уровень гетерогенности по цитохимическим признакам. Особенно разнообразна картина реакции на неспецифическую эстеразу: лимфоциты различаются размерами, формой, числом и локализацией окрашенного продукта реакции. Среди них присутствуют клетки, обладающие морфологическими и цитохимическими особенностями, по которым у наземных млекопитающих различаются лимфоциты наземных млекопитающих с различными иммунологическими свойствами и функциями. Эти характеристики отражают, по-видимому, и функциональную разнородность лимфоцитов морских млекопитающих.
3.3 Количественный анализ структуры популяции лимфоцитов крови афалин по цитохимическим признакам
Форма распределения лимфоцитов афалин по активности ферментов и содержанию нуклеиновых кислот разнообразна. Встречаются как одно-, так и многовершинные гистограммы. Лишь 16 из 126 распределений близки к нормальным по низким значениям показателей асимметрии и эксцесса (Р=0.99). Характерно, что среди распределений лимфоцитов по активности НЭ близких к нормальным не оказалось.
Положительные асимметрия и эксцесс свидетельствуют, что в популяции лимфоцитов крови афалин присутствует большая группа клеток с относительно низкими значениями цитохимических признаков и что группы лимфоцитов, различающиеся по цитохимическим характеристикам, сильно перекрываются (табл. 1). Вариабельность распределения по суммарному содержанию ДНК и РНК ниже, чем по активности ферментов, оно обладает наименьшей асимметрией. По-видимому, лимфоциты периферической крови афалин, как и исследованных в данном отношении видов наземных млекопитающих, различаются, главным образом, количеством РНК. Последнее подтверждается тем, что распределения лимфоцитов после обработки РНК-азой, в отличие от необработанных, унимодальны и сдвинуты влево.
Таблица 1 Статистические параметры суммарных распределений лимфоцитов афалин по активности ферментов и содержанию нуклеиновых кислот.
|
№ |
Реакции |
Количество клеток |
М±m, усл. ед. |
V, % |
As |
Ex |
|
1. |
НЭ |
2188 |
1.71+0.03 |
69.6+1.5 |
1.300+0.052 |
1.390+0.104 |
|
2. |
СДГ |
2700 |
0.75+0.01 |
67.9+1.3 |
1.075+0.047 |
1.354+0.094 |
|
3. |
НАДНр |
2700 |
1.60+0.02 |
60.1+1.1 |
1.018+0.047 |
0.917+0.094 |
|
4. |
НАДФНр |
2600 |
1.35+0.02 |
66.3+1.3 |
1.144+0.048 |
1.198+0.096 |
|
5. |
ДНК+РНК |
2400 |
5.08+0.02 |
17.1+0.3 |
0.598+0.050 |
1.320+0.100 |
Исходя из того, что гетерогенность по цитохимическим признакам рассматривается как проявление метаболических различий между субпопуляциями лимфоцитов с различными иммунологическими функциями, мы провели попарное сравнение гистограмм распределения лимфоцитов по различным признакам и по каждому из признаков в отдельности – с суммарными распределениями по критерию Колмогорова-Смирнова (λ). По общему числу сходных гистограмм (при определении степени сходства как по каждому признаку, так и между признаками) больные афалины отличаются и от здоровых, и от беременных (36.5%, 49.5% и 49.7%, соответственно, Р=0.99).
|
Из за большого объема этот материал размещен на нескольких страницах:
1 2 3 4 |


